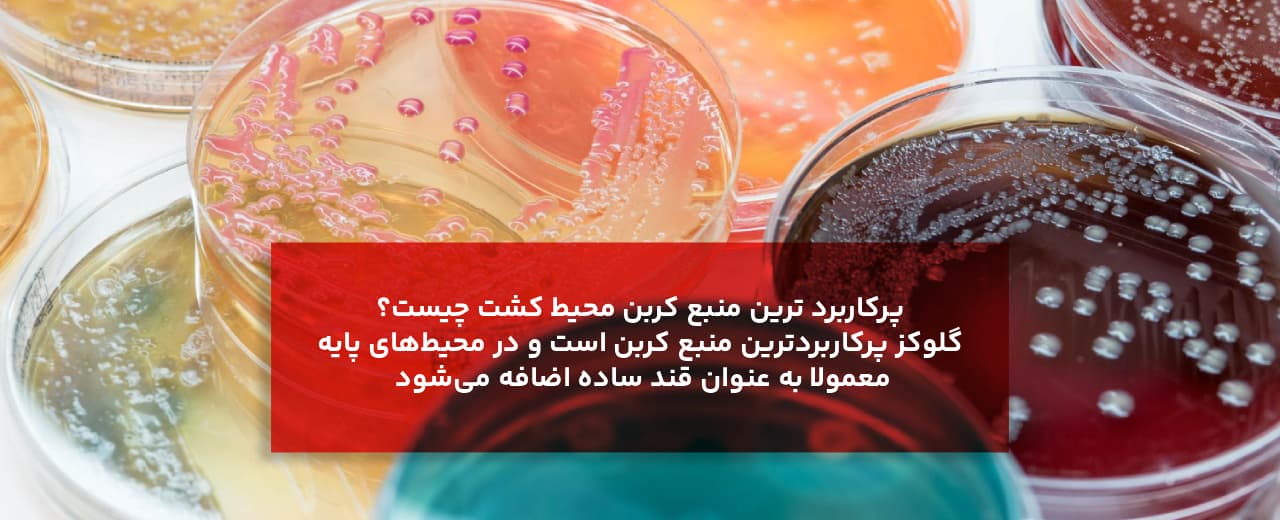
محیط کشت چیست؟ انواع محیط کشت، کاربردها و راهنمای خرید
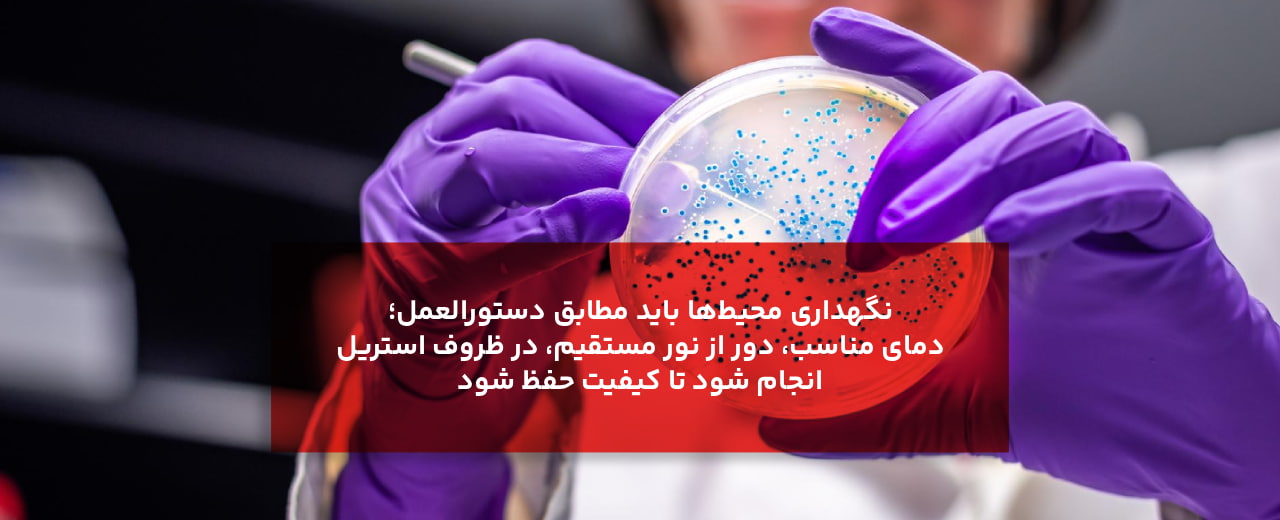
نکات عملی و ایمنی در انتخاب و کاربرد اجزای محیط کشت چیست؟
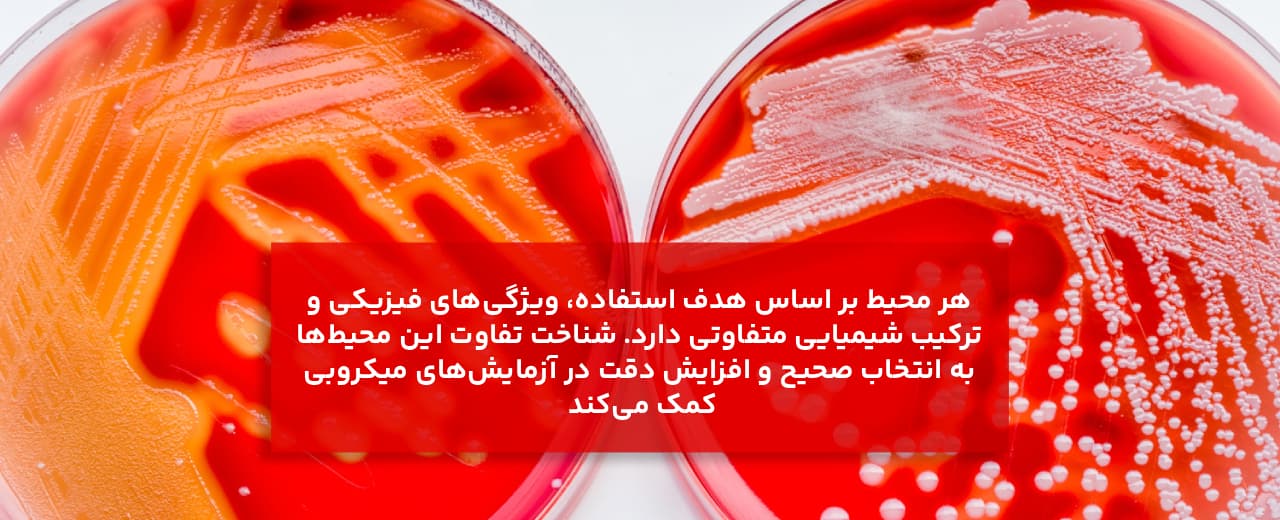
کاربرد انواع محیط کشت چیست؟
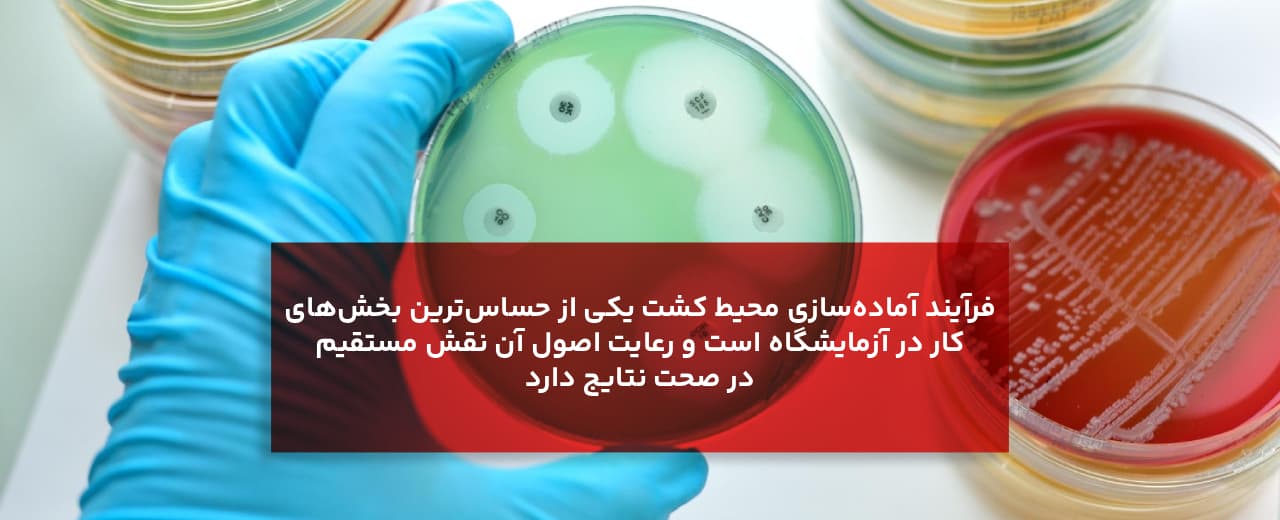
روش آمادهسازی محیط کشت چیست؟
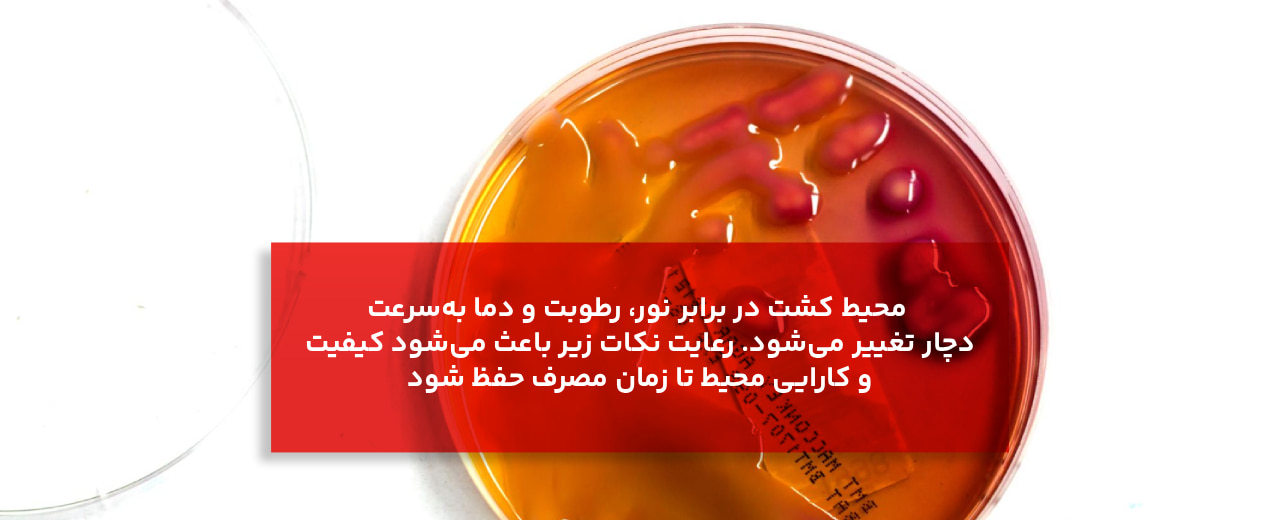
نکات نگهداری و کنترل کیفیت محیط کشت چیست؟

برای مشاهده لیست انواع محیط کشت برند مرک آلمان کلیک کنید.
محیط کشت چیست؟
محیط کشت به زبان ساده مادهای مغذی و کنترلشده است که برای رشد، تکثیر و شناسایی میکروارگانیسمها در شرایط آزمایشگاهی به کار میرود. این محیط، بستری شبیهسازیشده از شرایط طبیعی بدن، خاک یا هر محیط زیستی دیگر است تا میکروبها بتوانند در آن رشد کنند و رفتار طبیعی خود را نشان دهند. وقتی میپرسیم محیط کشت چیست، در واقع درباره ترکیبی صحبت میکنیم که حاوی تمام مواد ضروری برای حیات میکروارگانیسمهاست؛ از منابع انرژی و کربن گرفته تا مواد معدنی و فاکتورهای رشد.
محیطهای کشت میتوانند مایع یا جامد باشند و هرکدام برای هدف خاصی طراحی شدهاند؛ مثلا برای بررسی نوع باکتری، تشخیص بیماری، یا کنترل کیفیت محصولات غذایی و دارویی. بنابراین در پاسخ به سؤال محیط کشت چیست، باید گفت که این محیط نه تنها پایه اصلی علم میکروبیولوژی است، بلکه ابزاری کلیدی برای درک، شناسایی و مهار دنیای میکروبی محسوب میشود.
در ادامه این مقاله، بهصورت گامبهگام بررسی میکنیم که انواع محیط کشت چیست، از چه اجزایی تشکیل شده است و هرکدام چه کاربردی در آزمایشگاه دارند. با نواشیمی همراه بمانید تا همه چیز را درباره محیط کشت بهطور دقیق و کاربردی یاد بگیرید.
اجزای اصلی محیط کشت چیست؟ (راهنمای جامع شناخت اجزای محیط کشت)
در ادامه به معرفی اجزای اصلی انواع محیط کشت آزمایشگاهی خواهیم پرداخت:
۱. منبع کربن و انرژی
وظیفه: تأمین انرژی و اسکلت سلولی برای میکروارگانیسمها.
مثالها: گلوکز (دکستروز)، لاکتوز، اسکروز، گلیسرول.
نکات:
پرکاربرد ترین منبع کربن محیط کشت چیست؟ گلوکز پرکاربردترین منبع کربن است و در محیطهای پایه معمولا به عنوان قند ساده اضافه میشود.
برخی میکروارگانیسمها نیاز به قندهای خاص یا چندمنبعی دارند؛ برای نمونه بعضی باکتریهای لاکتوز-مثبت از لاکتوز استفاده میکنند و این تفاوت در محیطهای تفکیکی دیده میشود.
مقدار افزودنی قند معمولا به هدف آزمایش بستگی دارد (مثلا تنظیم میزان رشد سریع یا تشخیص تخمیر).
۲. منبع نیتروژن
وظیفه: ساخت پروتئینها، اسید نوکلئیک و سایر مولکولهای سلولی.
مثالها: پپتون، تریپتون، عصارههای گوشت یا مخمر، آمونیم سولفات (در محیطهای تعریفشده).
نکات:
پپتون و تریپتون از هیدرولیز پروتئینها به دست میآیند و حاوی ترکیبی از اسیدهای آمینه و پپتیدها هستند؛ به همین خاطر در انواع محیط کشت آزمایشگاهی پیچیده (complex) استفاده میشوند.
در محیطهای تعریفشده (synthetic/defined) از منابع نیتروژن مشخص مثل نیترات یا آمونیوم استفاده میشود تا شرایط کنترلشده برای بررسی متابولیسم ایجاد شود.
۳. منابع ویتامینها و فاکتورهای رشد محیط کشت چیست؟
وظیفه: تأمین ویتامینها، کوفاکتورها و اسیدهای آمینهای که برخی گونهها قادر به سنتزشان نیستند.
مثالها: عصاره مخمر (غنی از ویتامینهای گروه B)، بیوتین، نیاسین، اسیدهای آمینه ضروری.
نکات:
محیطهای غنی (enriched) مانند Blood agar یا Chocolate agar این فاکتورها را دارند و برای رشد میکروارگانیسمهای سخترویش ضروریاند.
در مطالعات ژنتیکی یا کشت سویههای جهشیافته، ممکن است فاکتورهای خاص را برای تکمیل جهش اضافه کنند.
۴. نمکهای معدنی و عناصر کمیاب
وظیفه: تأمین یونهای ضروری برای فعالیت آنزیمها و ثبات غشاها (مثل Na⁺، K⁺، Mg²⁺، Ca²⁺، Fe²⁺/Fe³⁺، PO₄³⁻).
مثالها: NaCl، K₂HPO₄، MgSO₄، CaCl₂، آهن به صورت نمکهای قابل جذب.
نکات:
غلظت یونها روی اسمز و تعادل یونی سلول موثر است؛ مثلا NaCl بالا میتواند برای باکتریهای هالوفیل مفید و برای سایرین مضر باشد.
بعضی محیطها برای آزمایشات ویژه (مثلا بافرهای فسفاتی) از نمکهای بافرشده استفاده میکنند تا pH پایدار بماند.
۵. عوامل جامدکننده (Solidifying agents)
وظیفه: تبدیل محیط مایع به حالت نیمهجامد یا جامد برای مشاهده کلنی و کارهای افتراقی.
مثالها: آگار (رایجترین)، ژلاتین (کماستفاده در میکروبیولوژی مدرن)، کاراژینان در برخی کاربردهای خاص.
نکات:
آگار معمولا ۱٫۰–۲٫۰ درصد وزن/حجم برای محیطهای جامد استفاده میشود (برای پلیتهای محیط کشت معمول حدود ۱٫۵ درصد رایج است).
آگار در دمای محیط جامد میماند و توسط بیشتر میکروبها هضم نمیشود؛ برای همین مادهٔ جامدکنندهٔ ایدهآلی است.
۶. بافرها و تنظیمکننده pH
وظیفه: حفظ pH مطلوب برای رشد میکروارگانیسم؛ بسیاری از آنزیمها در pH خاصی عملکرد بهینه دارند.
مثالها: فسفاتها (K₂HPO₄ / KH₂PO₄)، تریکس، هِپز (در محیطهای اختصاصی).
نکات:
pH اولیه محیط بسته به نوع میکروارگانیسم متفاوت است (مثلا باکتریهای معمولی اغلب در pH حدود 7.0 ± 0.2 رشد میکنند؛ قارچها ممکن است pH اسیدیتر ترجیح دهند).
تغییر pH در طول رشد میتواند نشاندهندهٔ متابولیسم (مثلا تولید اسید از تخمیر قند) باشد و در محیطهای تفکیکی از معرفهای pH استفاده میشود.
۷. عوامل انتخابی و بازدارنده (Selective agents)
وظیفه: سرکوب رشد برخی میکروارگانیسمها و انتخاب آنهایی که به مقاومت یا سویهٔ مورد نظر تعلق دارند.
مثالها: آنتیبیوتیکها، سالتهای صفراوی، اسیدها/بازها، رنگها (مثلا Crystal violet در MacConkey).
نکات:
این عوامل در محیطهای انتخابی به کار میروند؛ برای مثال MacConkey شامل سالت و رنگهایی است که بازیگرهای گراممنفی را تشویق و گراممثبت را مهار میکند.
غلظت و نوع عامل انتخابی باید دقیق تنظیم شود؛ غلظت زیاد ممکن است سویه هدف را نیز مهار کند.
۸. معرفها و عوامل تفکیکی (Indicators / Differential agents)
وظیفه: آشکارسازی واکنشهای متابولیکی و کمک به تمایز گونهها بر اساس تولید اسید، گاز یا آنزیم.
مثالها: فنل رد (indicator pH)، فتالئین، نمکهای خاصی که رسوب تولید میکنند، مواد رنگی در محیطهای تفکیکی.
نکات:
در محیطهایی مثل Blood agar یا MacConkey، تغییر رنگ یا هِمولیز کلنیها اطلاعات تشخیصی مهم میدهد.
انتخاب معرف مناسب بستگی به نوع واکنشی دارد که میخواهیم آشکار کنیم (تخمیر قند، تولید هیدروژن سولفید، لیپاز، کاتالاز و غیره).
۹. عوامل تثبیتکننده و ضدکف (Emulsifiers / stabilizers)
وظیفه: در برخی محیطها برای حفظ یکنواختی و جلوگیری از کف یا جداشدگی ترکیبات استفاده میشوند.
مثالها: پلیسورباتها در محیطهای حاوی فاز چربی یا در محیطهای حاوی ذرات معلق.
نکات: معمولا در محیطهای سادهٔ آزمایشگاهی خیلی رایج نیستند اما در محیطهای صنعتی یا محیطهای اختصاصی کاربرد دارند.
۱۰. آب و کیفیت آب (Water quality)
وظیفه: حلال اصلی برای تمام اجزای محیط؛ کیفیت آب تعیینکنندهٔ آلودگیهای میکروبی و یونهای مزاحم است.
نکات:
از آب مقطر یا آب آزمایشگاهی با هدایتپذیری کنترلشده استفاده کن. آب دیونیزه یا آب مقطر استریل برای آمادهسازی محیط پیشنهاد میشود.
آب آلوده یا دارای یونهای ناخواسته میتواند رشد را تغییر دهد یا معرفها را واکنشپذیر کند.
۱۱. مواد نگهدارنده و آنتیاکسیدانها (در صورت نیاز)
وظیفه: جلوگیری از فساد محیط یا اکسیداسیون ترکیبات حساس.
مثالها: بعضی محیطهای آمادهفروش ممکن است نگهدارندههای ملایمی داشته باشند؛ در محیطهای کشت حیاتی اغلب از نگهدارنده پرهیز میشود و به جای آن محیط تازه تهیه میشود.
نکات: در بیشتر انواع محیط آزمایشگاهی پرکاربرد برای کشتهای کلینیکی یا تحقیقاتی از نگهدارنده استفاده نمیشود چون میتواند بر رشد تاثیر بگذارد.
۱۲. عوامل گاز و شرایط اتمسفری
وظیفه: برخی باکتریها نیاز به شرایط خاص هوازی/بیهوازی یا غلظتهای CO₂ دارند.
نکات:
محیط به تنهایی تعیینکنندهٔ همه چیز نیست؛ شرایط انکوباسیون (دمای مناسب، حضور یا عدم حضور اکسیژن، CO₂) به همان اندازه حیاتی است.
برخی محیطها برای رشد بیهوازی با افزودن عوامل احیاءکننده یا استفاده از جارهای بیهوازی طراحی میشوند.
سریع ترین روش استعلام قیمت انواع محیط کشت چیست؟ شما می توانید از طریق خط ویژه 02192003669 با تیم فنی نُـوا شیمی همراه بمانید.
تأثیر ترکیب اجزا روی کاربرد محیط کشت چیست؟
محیطهای پیچیده (Complex media): حاوی عصارهها و پپتوناند؛ برای رشد عمومی مناسب و زمانی که نیاز به رشد سریع و غنی داریم.
محیطهای تعریفشده (Defined media): هر ماده با غلظت مشخص است؛ مناسب برای مطالعات متابولیکی و کنترل متغیرها.
محیطهای انتخابی/تفکیکی: با افزودن عوامل بازدارنده و معرفها برای جداسازی و شناسایی گونهها طراحی میشوند.
نکات عملی و ایمنی در انتخاب و کاربرد اجزای محیط کشت چیست؟
همیشه از مواد تازه و با کیت کیفیت مشخص استفاده کن؛ مواد فاسد یا آلوده نتیجهٔ کاذب میدهند.
هنگام افزودن عوامل حساس (مثل برخی ویتامینها یا آنتیبیوتیکها)، معمولا آنها را پس از استریل کردن پایه اضافه میکنند (filter-sterilize) تا از خرابشدن در اتوکلاو جلوگیری شود.
برای هر ترکیب، مستندات سازنده و پروتکلهای استاندارد را چک کنید — مقادیر و دستورالعملها بسته به هدف آزمایش تغییر میکنند.
نگهداری محیطها باید مطابق دستورالعمل (دمای مناسب، دور از نور مستقیم، در ظروف استریل) انجام شود تا کیفیت حفظ شود.
انواع محیط کشت چیست و هر کدام چه کاربردی دارند؟
برای درک درست اینکه محیط کشت چیست و چطور باید از آن استفاده شود، لازم است با انواع محیط کشت آشنا شویم. محیطهای کشت را میتوان بر اساس چند معیار اصلی طبقهبندی کرد: از نظر قوام (شکل فیزیکی)، از نظر ترکیب شیمیایی و از نظر کاربرد آزمایشگاهی. در ادامه هر دسته را به طور کامل بررسی میکنیم.
۱. تقسیمبندی از نظر قوام (شکل فیزیکی)
در ادامه به پاسخ این پرسخ خواهیم پرداخت که انواع محیط کشت آزمایشگاهی از نظر قوام یا شکل فیزیکی آن چیست:
الف) محیط مایع (Broth Media)
محیط مایع یا بروث بدون هیچ عامل جامدکنندهای است و برای رشد میکروارگانیسمها در حالت معلق استفاده میشود.
کاربرد محیط کشت مایع چیست؟
افزایش حجم سلولها برای استخراج یا بررسی متابولیتها
کشت اولیه برای تهیه سوسپانسیون باکتری قبل از انتقال به محیط جامد
نمونهها: Nutrient Broth، Tryptic Soy Broth.
ویژگی محیط کشت مایع: محیط مایع شفاف است و با رشد میکروارگانیسم کدر میشود. همین کدورت یکی از شاخصهای سنجش رشد است.
ب) محیط جامد (Solid Media)
این محیطها معمولا با افزودن آگار (حدود ۱٫۵ درصد) تهیه میشوند. میکروارگانیسمها روی سطح یا داخل آن رشد میکنند و کلنیهای مجزا تشکیل میدهند.
کاربرد محیط کشت جامد چیست؟
مشاهده شکل کلنی، رنگ و سایر ویژگیهای ظاهری
جداسازی گونههای مختلف از مخلوط نمونهها
بررسی خلوص و شناسایی دقیق باکتری
نمونهها: Nutrient Agar، MacConkey Agar، Blood Agar.
ج) محیط نیمهجامد (Semi-solid Media)
این محیطها مقدار کمتری آگار دارند (حدود ۰٫۳ تا ۰٫۵ درصد) و قوامی شبیه ژل نرم دارند.
کاربرد محیط کشت نیمه جامد چیست؟
بررسی تحرک باکتریها (motility test)
ایجاد شرایط بیهوازی نسبی در برخی کشتها
نمونهها: SIM Medium، Motility Test Medium.
سریع ترین روش استعلام قیمت انواع محیط کشت چیست؟ شما می توانید از طریق خط ویژه 02192003669 با تیم فنی نُـوا شیمی همراه بمانید.
۲. تقسیمبندی از نظر ترکیب شیمیایی
الف) محیط ساده یا پایه (Simple/Basal Media)
این محیطها برای رشد عمومی میکروارگانیسمهای غیرپیچیده طراحی شدهاند.
ترکیب: پپتون، عصاره گوشت، نمکهای معدنی و آب.
کاربرد این نوع محیط کشت چیست؟ کشت روتین باکتریهای غیرسخترویش مانند E. coli.
نمونهها: Nutrient Agar، Nutrient Broth.
ویژگی محیط کشت آزمایشگاهی ساده: پایه بسیاری از محیطهای اختصاصی از همین محیطهای ساده گرفته میشود.
ب) محیط ترکیبی یا پیچیده (Complex Media)
در این محیطها ترکیب دقیق شیمیایی مشخص نیست، چون از عصارههای طبیعی مثل عصاره مخمر یا عصاره گوشت استفاده میشود.
کاربرد این نوع محیط کشت چیست؟ رشد سریع و قویتر میکروبها در آزمایشهای عمومی یا صنعتی.
نمونهها: Tryptic Soy Broth، Brain Heart Infusion Agar.
ویژگی محیط کشت آزمایشگاهی ترکیبی: به دلیل تنوع مواد مغذی، تقریبا اکثر باکتریها در این محیطها رشد میکنند.
ج) محیط مصنوعی یا تعریفشده (Chemically Defined Media)
در این محیطها تمام ترکیبات و غلظت هر جزء بهصورت دقیق مشخص است.
کاربرد این نوع محیط کشت چیست؟ مطالعات بیوشیمیایی، بررسی مسیرهای متابولیکی، و تحقیقات ژنتیکی.
نمونهها: Synthetic minimal medium برای E. coli یا محیطهای تعریفشده برای قارچها.
ویژگی محیط کشت آزمایشگاهی مصنوعی: کنترل کامل بر متغیرهای آزمایش و حذف عوامل ناشناخته.
۳. تقسیمبندی از نظر کاربرد آزمایشگاهی
الف) محیط غنی (Enriched Media)
برای رشد میکروارگانیسمهایی که نیاز غذایی بالایی دارند یا در محیطهای ساده رشد نمیکنند، از محیط غنی استفاده میشود.
ترکیب: محیط پایه + مواد مغذی اضافی مانند خون، سرم، یا عصاره مخمر.
نمونهها: Blood Agar، Chocolate Agar.
کاربرد: کشت باکتریهای سخترویش مانند Neisseria و Streptococcus.
ویژگی: حاوی فاکتورهای رشد ضروری برای گونههای حساس.
ب) محیط انتخابی (Selective Media)
در پاسخ به اینکه محیط کشت انتخابی چیست باید گفت محیطی است که رشد برخی گونهها را مهار کرده و فقط اجازه رشد به گونههای هدف میدهد.
ترکیب: محیط پایه + عوامل بازدارنده مثل رنگ، نمک، یا آنتیبیوتیک.
نمونهها:
MacConkey Agar: برای رشد باکتریهای گرممنفی و مهار گرممثبتها.
Mannitol Salt Agar: مناسب برای استافیلوکوکها به دلیل وجود نمک بالا.
ویژگی: به شناسایی گروه خاصی از میکروارگانیسمها کمک میکند.
ج) محیط تفکیکی یا افتراقی (Differential Media)
این محیطها علاوه بر رشد، به تشخیص تفاوت گونهها بر اساس واکنش متابولیکی کمک میکنند.
ترکیب: معرفهای رنگی یا ترکیباتی که در اثر متابولیسم تغییر ظاهر میدهند.
نمونهها:
MacConkey Agar: کلنیهای لاکتوزتخمیرکننده را صورتی نشان میدهد.
Blood Agar: نوع همولیز باکتری را مشخص میکند.
ویژگی: در آزمایشگاههای تشخیص طبی کاربرد گسترده دارد.
د) محیط انتقال (Transport Media)
این محیطها برای حفظ زندهمانی میکروارگانیسمها بین نمونهگیری و آزمایش طراحی شدهاند، بدون اینکه موجب رشد زیاد شوند.
نمونهها: Stuart Medium، Amies Medium.
کاربرد: انتقال نمونههای بالینی مانند سوآب حلق، ترشحات، یا ترشحات واژینال به آزمایشگاه.
ویژگی: ترکیب متعادل و غیرفرآورنده دارد تا باکتری تا زمان بررسی زنده بماند.
ه) محیط اختصاصی (Special Purpose Media)
برای جداسازی یا شناسایی میکروارگانیسم خاص طراحی میشوند.
نمونهها:
Lowenstein–Jensen Medium: برای مایکوباکتریوم (عامل سل).
Thayer–Martin Medium: برای Neisseria gonorrhoeae.
Sabouraud Dextrose Agar: برای قارچها و مخمرها.
ویژگی: ترکیب دقیق آن با هدف شناسایی و رشد گونهٔ خاص تنظیم شده است.
و) محیط نگهداری (Maintenance / Preservation Media)
برای نگهداری طولانیمدت میکروارگانیسمها بدون تغییر ژنتیکی استفاده میشود.
نمونهها: Nutrient Agar slant، محیط گلیسیرول، محیطهای منجمد در -80°C.
کاربرد: حفظ سویههای مرجع و ذخیرهسازی نمونهها در بانک میکروبی.
در صورت تمایل به دریافت اطلاعات فروش محیط کشت آزمایشگاهی از طریق خط ویژه 02192003669 با نُـوا شیمی همراه بمانید.
۴. کاربرد انواع محیط کشت چیست؟ (خلاصه مطالب)
در ادامه، مختصرا کاربرد های انواع محیط کشت آزمایشگاهی را مطالعه خواهیم نمود:
| نوع محیط کشت | هدف اصلی | نمونههای رایج |
|---|---|---|
| ساده | رشد عمومی | Nutrient agar |
| غنی | رشد میکروبهای سخترویش | Blood agar |
| انتخابی | حذف رشد گونههای غیرهدف | Mannitol salt agar |
| تفکیکی | تشخیص واکنش متابولیکی | MacConkey agar |
| انتقال | زنده نگه داشتن باکتری در مسیر آزمایش | Stuart medium |
| اختصاصی | رشد گونه خاص | Lowenstein–Jensen |
| نگهداری | حفظ سویه برای مدت طولانی | Nutrient slant |
در نتیجه، در پاسخ به این پرسش که انواع محیط کشت چیست باید گفت هر محیط بر اساس هدف استفاده، ویژگیهای فیزیکی و ترکیب شیمیایی متفاوتی دارد. شناخت تفاوت این محیطها به انتخاب صحیح، کاهش خطا و افزایش دقت در آزمایشهای میکروبی کمک میکند.
راهنمای جامع خرید و انتخاب محیط کشت
انتخاب محیط کشت مناسب، یکی از مهمترین مراحل در هر آزمایش میکروبی است؛ چون حتی با داشتن تجهیزات دقیق، اگر محیط کشت بهدرستی انتخاب نشود، نتیجه آزمایش قابل اعتماد نخواهد بود. بنابراین پیش از خرید باید بدانیم چه نوع میکروارگانیسمی قرار است کشت داده شود، هدف آزمایش چیست و در چه شرایطی انجام میشود. در ادامه به مهمترین معیارها برای انتخاب و خرید محیط کشت اشاره میکنیم:
۱. تعیین نوع میکروارگانیسم هدف
پیش از هر چیز باید مشخص شود که قرار است باکتری، قارچ، ویروس یا جلبک کشت داده شود، چون هر گروه نیاز غذایی و شرایط متفاوتی دارد.
برای باکتریها: معمولا از محیطهای عمومی مثل Nutrient agar یا Tryptic Soy Agar استفاده میشود.
برای قارچها و مخمرها: محیطهایی مثل Sabouraud Dextrose Agar (SDA) یا Potato Dextrose Agar (PDA) مناسباند.
برای باکتریهای سخترویش یا حساس: محیطهای غنی مانند Blood agar یا Chocolate agar ضروری هستند.
۲. هدف از کشت و نوع آزمایش
باید مشخص شود که هدف از کشت چیست؛ تشخیص، جداسازی، نگهداری، شمارش یا مطالعه متابولیک.
اگر هدف تشخیص گونه خاص باشد، از محیطهای اختصاصی یا تفکیکی استفاده میشود.
اگر هدف جداسازی از نمونه آلوده است، محیط انتخابی بهترین گزینه است.
برای نگهداری سویهها، محیطهای ساده و پایدار مانند Nutrient slant مناسباند.
برای بررسی رشد یا تولید ماده خاص، محیطهای تعریفشده و کنترلشده استفاده میشوند.
در صورت تمایل به دریافت اطلاعات فروش محیط کشت آزمایشگاهی از طریق خط ویژه 02192003669 با نُـوا شیمی همراه بمانید.
۳. بررسی ترکیب شیمیایی و فرمول محیط
در هنگام خرید محیط کشت باید به برچسب محصول و ترکیب آن توجه کرد. محیطهایی که از منابع باکیفیت ساخته میشوند، نتایج دقیقتری ارائه میدهند.
محیطهای پودری آماده (Dehydrated Culture Media) معمولا با ترکیب استاندارد و قابل اعتماد تولید میشوند و تنها کافی است طبق دستور سازنده آماده شوند.
از خرید محیطهای فاقد مشخصات ترکیب یا فاقد تاریخ تولید و انقضا باید خودداری کرد.
۴. کیفیت تولیدکننده و برند سازنده
کیفیت محیط کشت تا حد زیادی به برند و استاندارد تولید آن بستگی دارد.
برندهای معتبر جهانی مثل HIMEDIA، Merck، Oxoid، Difco و Condalab شناختهشدهترین تولیدکنندگان محیطهای کشت آزمایشگاهی هستند.
در بازار ایران نیز شرکتهایی مثل نُـوا شیمی نمایندگی یا واردکننده رسمی این برندها هستند.
هنگام خرید، حتما به موارد زیر دقت کن:
دارا بودن گواهی کیفیت (COA)
شماره بچ (Batch No) برای پیگیری و مقایسه نتایج
پلمپ بودن بستهبندی و شرایط نگهداری مناسب
۵. شکل عرضه محیط کشت
محیطهای کشت به دو شکل اصلی در بازار عرضه میشوند:
پودری (Dehydrated): رایجترین نوع که باید قبل از استفاده در آزمایشگاه آماده و استریل شود.
آماده مصرف (Ready to Use): به صورت پلیت یا تیوپ استریلشده عرضه میشود؛ مناسب برای آزمایشگاههایی که حجم بالای نمونه دارند یا زمان محدود دارند.
اگر محیط در حجم زیاد استفاده میشود، خرید نوع پودری اقتصادیتر است. برای کارهای تشخیصی سریع یا مراکز درمانی، محیطهای آماده مصرف انتخاب بهتری هستند.
در صورت تمایل به دریافت اطلاعات فروش محیط کشت آزمایشگاهی از طریق خط ویژه 02192003669 با نُـوا شیمی همراه بمانید.
6. بررسی شرایط نگهداری و انقضا
بیشتر محیطهای پودری باید در محیط خشک و خنک، به دور از نور مستقیم نگهداری شوند.
محیطهای آماده باید در دمای ۲ تا ۸ درجه سانتیگراد در یخچال نگهداری شوند.
هرگز از محیطی که تغییر رنگ، بوی غیرعادی یا آلودگی ظاهری دارد استفاده نکنید، حتی اگر تاریخ انقضا هنوز نگذشته باشد.
۷. بررسی شرایط استریلیزاسیون
اگر محیط به صورت پودری خریداری میشود، باید بعد از آمادهسازی در اتوکلاو با دمای ۱۲۱ درجه و فشار ۱۵ پوند بر اینچ مربع به مدت ۱۵ تا ۲۰ دقیقه استریل شود.
برای محیطهای حساس (مثلا حاوی آنتیبیوتیک یا ویتامینها)، این ترکیبات باید بعد از اتوکلاو و در شرایط استریل به محیط اضافه شوند.
۸. انتخاب حجم و بستهبندی مناسب
محیطها معمولاً در بستههای ۵۰۰ گرمی، ۱ کیلویی یا پلیتهای آماده در تعداد مشخص عرضه میشوند.
برای مصرف کم و آزمایشگاههای آموزشی، بستههای کوچکتر کافیاند.
برای مصرف صنعتی یا بیمارستانی، خرید بستههای بزرگتر از نظر اقتصادی بهصرفهتر است.
۹. مشاوره قبل از خرید
در صورت شک درباره انتخاب محیط، بهتر است از کارشناسان فنی یا فروشگاههای تخصصی آزمایشگاهی مشاوره بگیری.
مراکز تخصصی مثل نواشیمی معمولا اطلاعات فنی، برگه مشخصات و دستور آمادهسازی هر محیط را در اختیار خریدار قرار میدهند تا انتخاب دقیقتری انجام شود.
در نهایت، انتخاب صحیح محیط کشت باید بر پایه شناخت دقیق میکروارگانیسم، هدف آزمایش و شرایط کاری باشد.
استفاده از محیط بیکیفیت یا ناسازگار میتواند باعث رشد ناقص، آلودگی یا خطای تشخیص شود.
با نواشیمی همراه بمانید تا در بخش بعدی یاد بگیریم چگونه محیط کشت را مرحلهبهمرحله آماده کنیم و نکات استریلسازی و نگهداری حرفهای را بیاموزیم.
در صورت تمایل به دریافت اطلاعات فروش محیط کشت آزمایشگاهی از طریق خط ویژه 02192003669 با نُـوا شیمی همراه بمانید.
روش آمادهسازی محیط کشت چیست؟ (مرحلهبهمرحله)
برای درک بهتر اینکه محیط کشت چیست و چگونه آماده میشود، باید بدانیم هر محیط کشت از ترکیبات مشخصی تشکیل شده که باید با دقت در شرایط استریل آماده شوند. فرایند آمادهسازی محیط کشت یکی از حساسترین بخشهای کار در آزمایشگاه است و رعایت اصول آن نقش مستقیم در صحت نتایج دارد. در ادامه مراحل آمادهسازی را بهصورت کامل توضیح میدهیم:
۱. شناخت نوع محیط کشت مورد نیاز
پیش از شروع باید بدانیم محیط کشت چیست و چه نوعی برای هدف ما مناسب است.
به عنوان مثال:
اگر هدف، رشد عمومی باکتریهاست، از محیط ساده مثل Nutrient Agar استفاده میشود.
برای جداسازی میکروارگانیسم خاص، محیط انتخابی یا اختصاصی انتخاب میشود.
بنابراین پیش از هر چیز، نوع محیط بر اساس نوع میکروارگانیسم و هدف آزمایش تعیین میشود.
۲. آمادهسازی مواد اولیه
پس از تعیین نوع محیط، باید مواد اولیه آن مطابق دستور سازنده آماده شوند.
محیطهای کشت بهصورت پودر آماده در بستهبندیهای استاندارد عرضه میشوند. مراحل زیر باید رعایت شود:
1. مقدار مشخصی از پودر محیط کشت را با ترازوی دقیق وزن کنید.
2. آن را در مقدار مناسب آب مقطر (معمولاً بین ۱ تا ۲ درصد وزن محیط) حل کنید.
3. در صورت نیاز، pH محلول را مطابق دستور تنظیم کنید.
۳. حرارتدهی برای حل کامل پودر
بیشتر محیطها در آب سرد بهطور کامل حل نمیشوند. بنابراین باید با حرارت ملایم روی هیتر یا بنماری قرار گیرند تا کاملاً شفاف شوند.
در این مرحله، نباید جوش بیش از حد ایجاد شود چون ممکن است ترکیبات حساس تخریب شوند.
این بخش اهمیت زیادی دارد چون حل کردن به روش نادرست می تواند سبب شود تا، مواد مغذی در محلول تهنشین شدهو رشد باکتری ناقص بماند.
۴. تقسیم محیط در ظروف مناسب
پس از حل کامل، محیط را در ظرفهای مقاوم به حرارت مانند ارلن یا فلاسک ریخته و درپوش آن را با فویل یا درب مخصوص ببندید.
اگر قصد دارید محیط را بهصورت پلیت آماده کنید، در این مرحله آن را هنوز در پلیت نریزید تا پس از استریلیزاسیون انجام شود.
در صورت تمایل به دریافت اطلاعات فروش محیط کشت آزمایشگاهی از طریق خط ویژه 02192003669 با نُـوا شیمی همراه بمانید.
۵. استریلیزاسیون محیط کشت
برای آنکه دقیقتر بفهمیم محیط کشت چیست و چرا باید استریل شود، باید بدانیم که هرگونه آلودگی خارجی میتواند نتایج کشت را بهطور کامل خراب کند.
به همین دلیل، محلول محیط باید در اتوکلاو (Autoclave) در دمای ۱۲۱ درجه سانتیگراد و فشار ۱۵ psi به مدت ۱۵ تا ۲۰ دقیقه استریل شود.
در محیطهای حساس به گرما، میتوان از فیلتراسیون استریل استفاده کرد.
۶. ریختن محیط در پتری دیش یا لوله آزمایش
بعد از استریلیزاسیون و زمانی که دمای محیط حدود ۴۵ تا ۵۰ درجه سانتیگراد است، آن را در پتری دیش برای محیط جامد یا در تیوب آزمایش برای محیط نیمهجامد بریزید.
در این مرحله نیز باید درک کنیم که محیط کشت چیست و چگونه باید بهصورت استریل منتقل شود، پس این کار حتما باید در زیر هود لامینار فلو (Laminar Flow Hood) انجام شود تا از ورود ذرات معلق جلوگیری شود.
۷. خشکسازی و انجماد محیط کشت
بعد از ریختن در پلیت، اجازه دهید تا محیط بهطور کامل بسته و جامد شود. سپس در صورت نیاز چند ساعت در دمای اتاق باقی بماند تا سطح آن خشک شود.
این کار از رشد ناخواسته قارچها جلوگیری میکند.
درک درست از این مرحله کمک میکند تا بدانیم محیط کشت چیست و چرا شرایط فیزیکی آن بر رشد میکروارگانیسمها تأثیر دارد.
۸. برچسبگذاری و نگهداری
پس از آمادهسازی کامل، هر پلیت یا تیوب باید برچسبگذاری شود (نام محیط، تاریخ، و شماره بچ).
محیطهای آماده معمولا در دمای ۲ تا ۸ درجه سانتیگراد قابل نگهداری هستند.
اگر محیط تغییر رنگ، بوی غیرعادی یا آلودگی نشان داد، نباید مورد استفاده قرار گیرد.
چنین نکاتی دقیقا نشان میدهد که محیط کشت چیست و چرا رعایت اصول نگهداری آن حیاتی است.
در صورت تمایل به دریافت استعلام قیمت محیط کشت آزمایشگاهی مرک از طریق خط ویژه 02192003669 با نُـوا شیمی همراه بمانید.
نکات حرفهای در آمادهسازی محیط کشت چیست؟
همیشه از آب مقطر تازه و تمیز استفاده کنید.
pH محیط را پس از اتوکلاو دوباره بررسی کن، چون ممکن است کمی تغییر کند.
از وسایل استریلشده با شعله یا اتوکلاو برای انتقال و ریختن محیط استفاده کنید.
در پایان هر مرحله، سطح کار را با الکل ۷۰٪ ضدعفونی کنید.
نکات نگهداری و کنترل کیفیت محیط کشت چیست؟
برای آنکه بهتر درک کنیم محیط کشت چیست و چگونه باید از آن نگهداری کرد، باید بدانیم این ماده بسیار حساس است و در برابر نور، رطوبت و دما بهسرعت دچار تغییر میشود. رعایت نکات زیر باعث میشود کیفیت و کارایی محیط تا زمان مصرف حفظ شود:
۱. شرایط نگهداری
محیطهای پودری را در جای خشک، خنک و دور از نور مستقیم نگهداری کنید.
محیطهای آماده مصرف باید در دمای ۲ تا ۸ درجه سانتیگراد (یخچال آزمایشگاهی) نگهداری شوند.
هرگز از محیطی که تغییر رنگ، بوی غیرعادی یا آلودگی سطحی دارد استفاده نکنید.
۲. کنترل کیفیت قبل از استفاده
برای اطمینان از اینکه محیط کشت چیست و سالم است یا نه، همیشه قبل از استفاده بررسی کنید:
ظاهر محیط باید شفاف و بدون ذرات باشد.
pH باید مطابق دستور سازنده باشد.
در آزمایش کنترل، رشد باکتری شاخص باید طبیعی و یکنواخت باشد.
۳. مدت زمان ماندگاری
محیطهای پودری معمولا تا ۲ سال قابل نگهداری هستند.
محیطهای آماده در پلیت، حداکثر ۲ تا ۴ هفته در یخچال قابل استفادهاند.
همیشه تاریخ انقضا و شماره بچ (Batch No) را هنگام مصرف بررسی کنید.
۴. خطاهای رایج در نگهداری
باز گذاشتن درب ظرف محیط در هوای آزاد
تماس مستقیم با دست یا وسایل غیراستریل
نگهداری در دمای بالا یا در مجاورت نور
این موارد میتوانند موجب آلودگی یا تغییر خصوصیات شیمیایی شوند و در نتیجه باعث شود محیط کشت چیست و چه کاربردی دارد بهدرستی قابل تشخیص نباشد.
برای حفظ کیفیت نتایج آزمایش، لازم است بدانیم محیط کشت چیست، چگونه باید نگهداری و بهموقع کنترل شود. رعایت این اصول، از بروز آلودگی، رشد ناقص یا خطای تشخیص جلوگیری میکند و باعث افزایش دقت در آزمایشهای میکروبی میشود.
با نواشیمی همراه بمانید؛
اگر بهدنبال محیط کشت باکیفیت، تازه و مطابق با استانداردهای بینالمللی هستید، نواشیمی مجموعهای کامل از محیطهای کشت پودری و آماده مصرف از برندهای معتبر جهانی را در اختیار شما قرار میدهد.
روشهای استعلام قیمت محیط کشت مرک آلمان از نواشیمی:
تماس تلفنی مستقیم
با خط ویژه 02192003669 تماس بگیرید و از قیمت، موجودی و شرایط ارسال مطلع شوید.
استفاده از صفحه «تماس با ما» در وبسایت
با ورود به صفحه تماس با ما، میتوانید به اطلاعات تماس، شماره تلفنها، آدرس ایمیل و مسیرهای ارتباطی دسترسی داشته باشید.
فرم درخواست پشتیبانی آنلاین
از فرم موجود در سایت برای ارسال درخواست قیمت و مشاوره تخصصی استفاده کنید. کارشناسان نواشیمی در سریعترین زمان پاسخ شما را خواهند داد.




